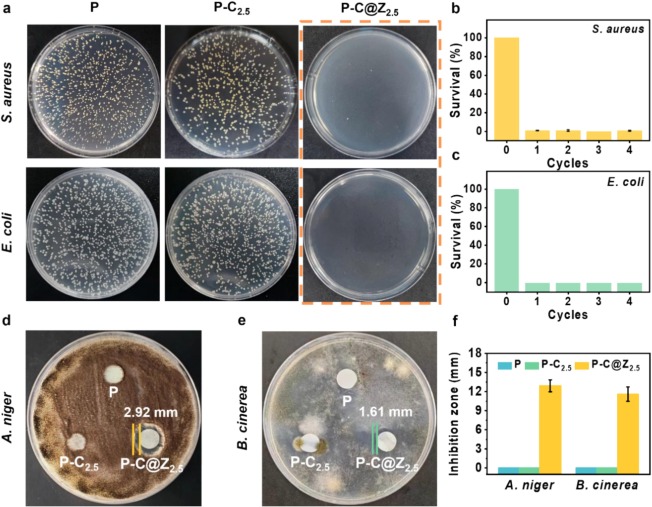
Carboxylated cellulose nanocrystals mediated flower-like zinc

リクエスト Carboxylated cellulose nanocrystals mediated flower-like zinc
(3549件)
Pontaパス特典
サンキュー配送
28095円(税込)
281ポイント(1%)
Pontaパス会員ならさらに+1%ポイント還元!
送料
(
)
3542
配送情報
お届け予定日:2026.04.27 23:59までにお届け
※一部地域・離島につきましては、表示のお届け予定日期間内にお届けできない場合があります。
ロットナンバー
64039150975
お買い物の前にチェック!

Pontaパス会員なら
ポイント+1%
ポイント+1%
商品説明

リクエスト品です
| カテゴリー: | 車・バイク・自転車>>>パーツ>>>その他 |
|---|---|
| 商品の状態: | 新品、未使用","新品で購入し、一度も使用していない |
| 配送料の負担: | 送料込み(出品者負担) |
| 配送の方法: | 佐川急便/日本郵便 |
| 発送元の地域: | 未定 |
| 発送までの日数: | 1~2日で発送 |
レビュー
商品の評価:




 5.0点(3549件)
5.0点(3549件)
- teru0328
- 良い商品です 自分の自転車の場合は後ろブレーキを1番効く位置で止めて前ブレーキで調整して何度か乗っては更に微調整をして前後がちゃんと効くように調整しました 腕の治療のためには仕方ないと思いました
- ryocan-mama
- 補助ブレーキはカッコ悪いかと思ってたけど街乗りでは便利でした。
- rhr7752
- 機能面はこの価格で十分いいと思います! おすすめです!
- チョウ6603
- ブレーキレバーの形状(曲線)が、とても手にフィットしています。そして何より低コストで購入できた事と取り付けが簡単な事、全てにおいてGoodでした。
すべて見る
お店の情報
7,367
連絡・応対
4.3
配送スピード
4.3
梱包
4.3